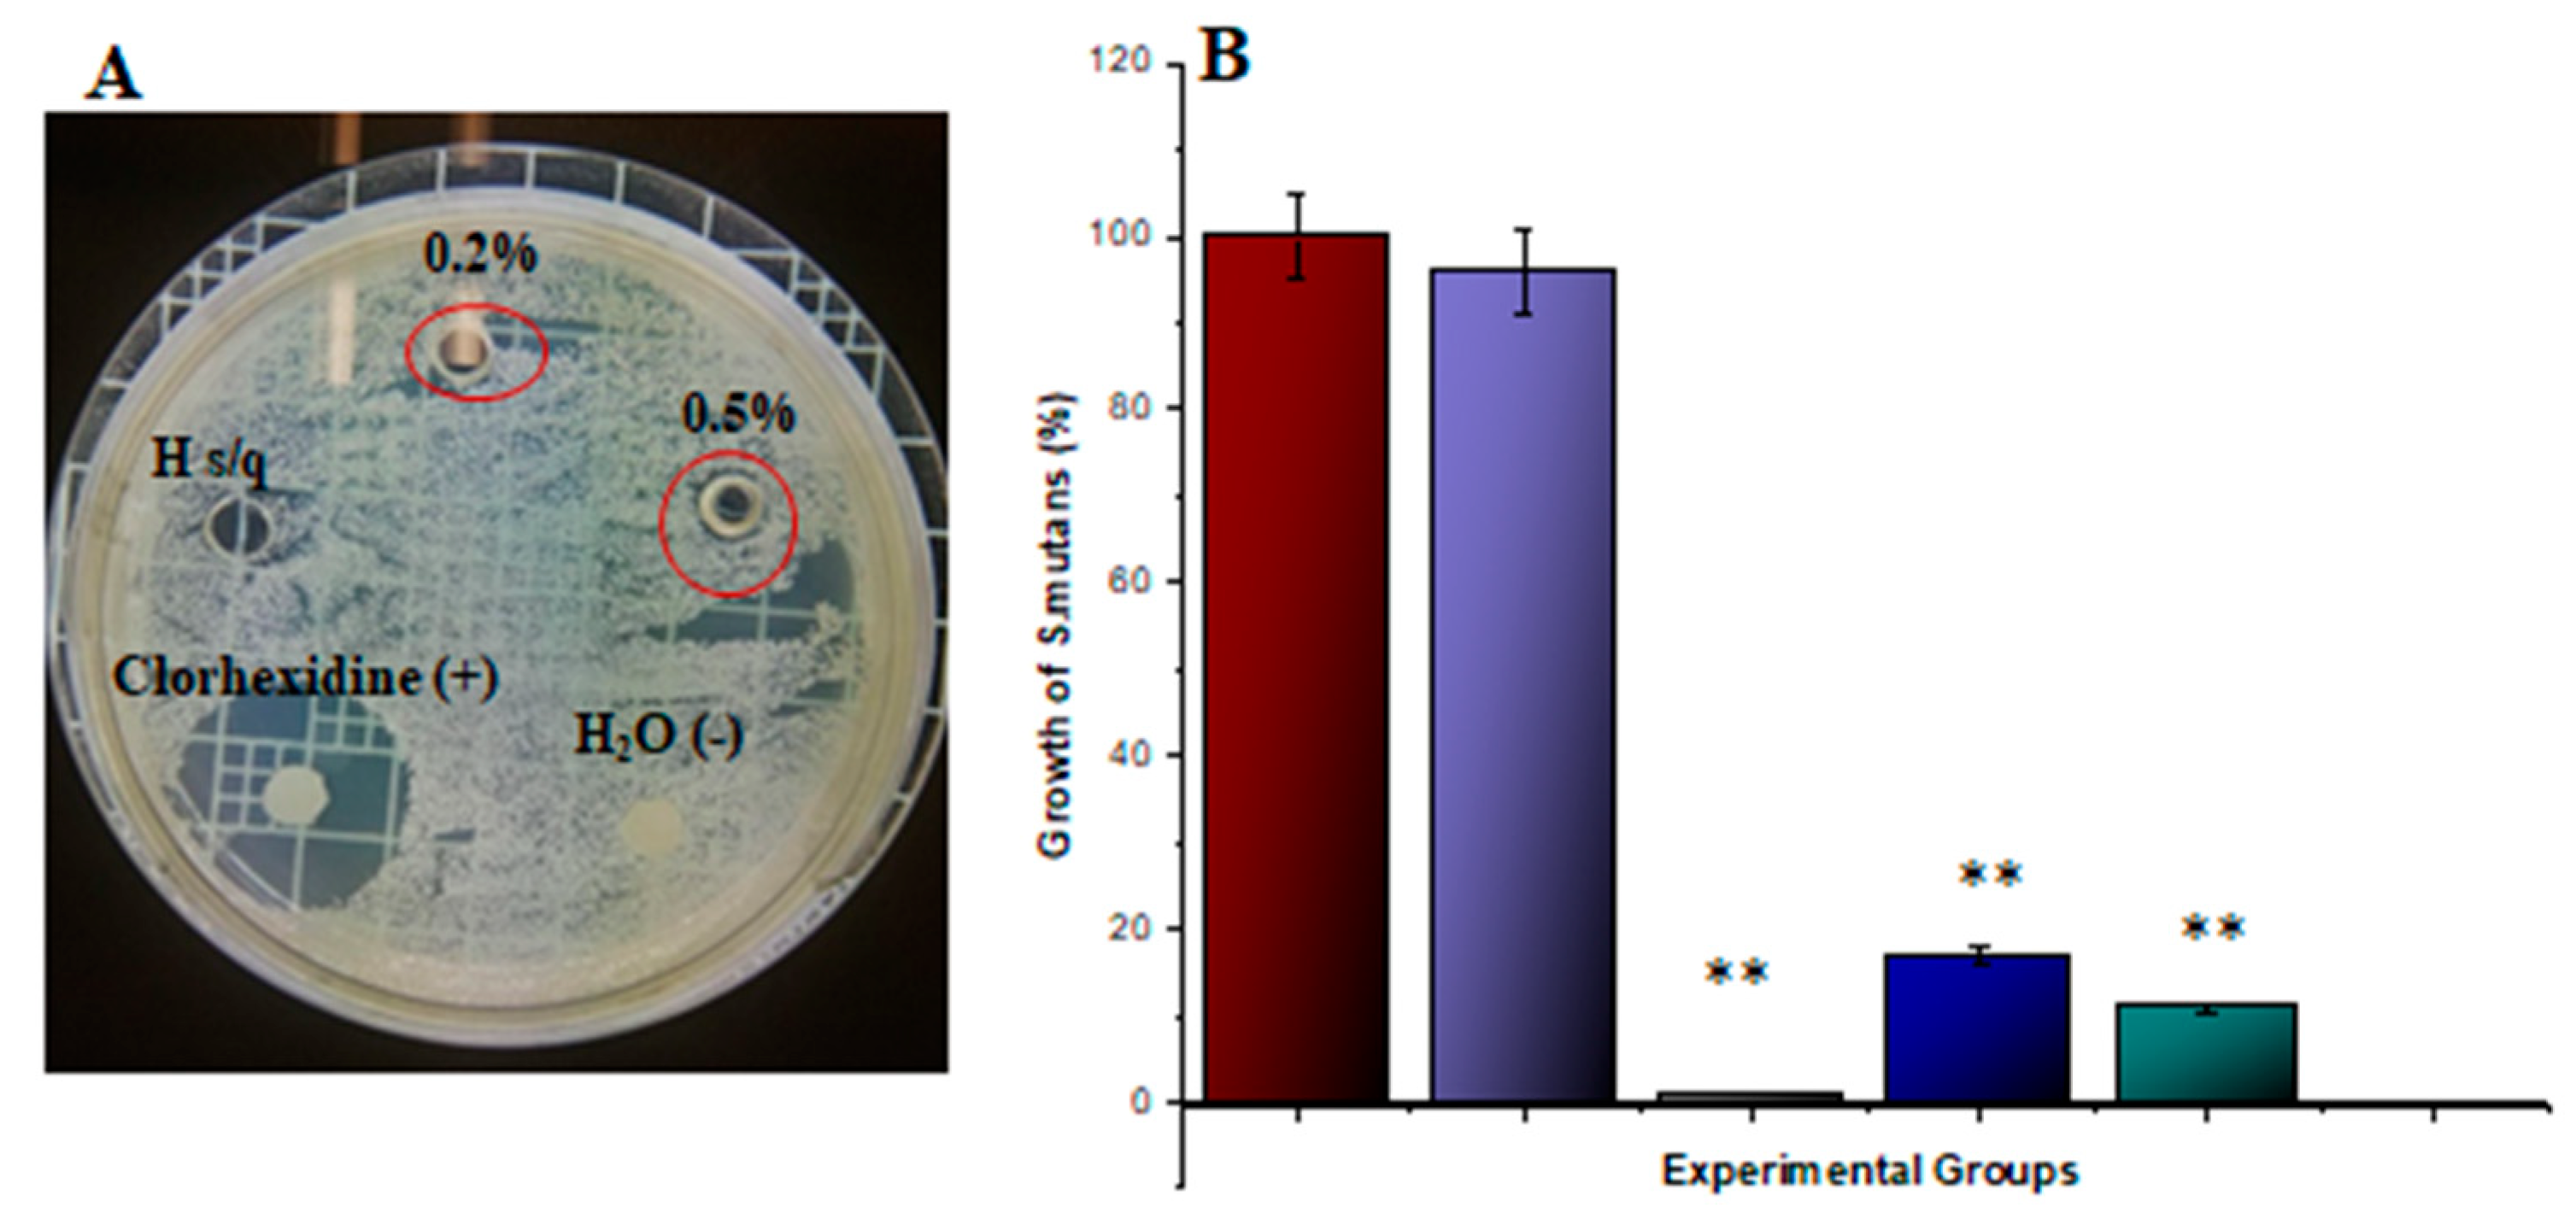
Biomimetics 08 00575 g006

Gelatin–Chitosan Hydrogel Biological, Antimicrobial and Mechanical Properties for Dental Applications
Abstract
:1. Introduction
2. Materials and Methods
2.1. Materials and Equipment
2.2. Gelatin–Chitosan Hydrogel Preparation
2.3. Hydrolytic and Enzymatic Degradation
2.4. Gelatin–Chitosan Hydrogel Characterization Using FTIR
2.5. Gelatin–Chitosan Hydrogel Swelling
2.6. SCAPs Cell Culture and Characterization
2.7. Gelatin–Chitosan Hydrogel SCAPs Interaction and Proliferation
2.8. Antimicrobial Activity of Gelatin–Chitosan Hydrogels
2.9. Gelatin–Chitosan Hydrogel Uniaxial Tensile Strength (UTS)
2.10. Statistical Analysis
3. Results
3.1. Degradation of the Gelatin–Chitosan Hydrogels
3.2. Gelatin–Chitosan Hydrogel Characterization Using FTIR
3.3. Gelatin–Chitosan Hydrogel Swelling Capacity
3.4. SCAPs Characterization
3.5. Gelatin–Chitosan Hydrogel SCAPs Interaction and Proliferation
3.6. Gelatin–Chitosan Hydrogel Antibacterial Effect
3.7. Gelatin–Chitosan Hydrogel Uniaxial Tensile Strength (UTS)
4. Discussion
4.1. Gelatin–Chitosan Hydrogel Preparation
4.2. Gelatin–Chitosan Hydrogel Degradation
4.3. Gelatin–Chitosan Hydrogel Characterization Using FTIR
4.4. Gelatin–Chitosan Hydrogel Swelling Capacity
4.5. SCAPs Characterization
4.6. Gelatin–Chitosan Hydrogel SCAPs Interaction and Proliferation
4.7. Gelatin–Chitosan Hydrogel Antimicrobial Effect
4.8. Gelatin–Chitosan Hydrogel Uniaxial Tensile Strength
5. Conclusions
Author Contributions
Funding
Institutional Review Board Statement
Data Availability Statement
Acknowledgments
Conflicts of Interest
References
- Gao, L.; Xu, T.; Huang, G.; Jiang, S.; Gu, Y.; Chen, F. Oral Microbiomes: More and More Importance in Oral Cavity and Whole Body. Protein Cell 2018, 9, 488–500. [Google Scholar] [CrossRef] [PubMed]
- Knight, E.; Przyborski, S. Advances in 3D Cell Culture Technologies Enabling Tissue-Like Structures to be Created In Vitro. J. Anat. 2015, 227, 746–756. [Google Scholar] [CrossRef] [PubMed]
- Xu, K.-P.; Li, X.-F.; Yu, F.-S.X. Corneal Organ Culture Model for Assessing Epithelial Responses to Surfactants. Toxicol. Sci. 2000, 58, 306–314. [Google Scholar] [CrossRef] [PubMed]
- Hira, V.V.V.; Breznik, B.; van Noorden, C.J.F.; Lah, T.; Molenaar, R.J. 2D and 3D in Vitro Assays to Quantify the Invasive Behavior of Glioblastoma Stem Cells in Response to SDF-1. BioTechniques 2020, 69, 339–346. [Google Scholar] [CrossRef] [PubMed]
- Noonan, J.; Grassia, G.; MacRitchie, N.; Garside, P.; Guzik, T.J.; Bradshaw, A.C.; Maffia, P. A Novel Triple-Cell Two-Dimensional Model to Study Immune-Vascular Interplay in Atherosclerosis. Front. Immunol. 2019, 10, 849. [Google Scholar] [CrossRef]
- Haycock, J.W. 3D Cell Culture: A Review of Current Approaches and Techniques. In 3D Cell Culture; Methods in Molecular Biology Methods; Humana Press: Totowa, NJ, USA, 2011; Volume 695, pp. 1–15. [Google Scholar] [CrossRef]
- Zamudio-Ceja, R.B.; Garcia-Contreras, R.; Chavez-Granados, P.A.; Aranda-Herrera, B.; Alvarado-Garnica, H.; Jurado, C.A.; Fischer, N.G. Decellularized Scaffolds of Nopal (Opuntia Ficus-indica) for Bioengineering in Regenerative Dentistry. J. Funct. Biomater. 2023, 14, 252. [Google Scholar] [CrossRef]
- Araujo, H.C.; da Silva, A.C.G.; Paião, L.I.; Magario, M.K.W.; Frasnelli, S.C.T.; Oliveira, S.H.P.; Pessan, J.P.; Monteiro, D.R. Antimicrobial, Antibiofilm and Cytotoxic Effects of a Colloidal Nanocarrier Composed by Chitosan-coated Iron Oxide Nanoparticles Loaded with Chlorhexidine. J. Dent. 2020, 101, 103453. [Google Scholar] [CrossRef]
- Xu, X.; Gu, Z.; Chen, X.; Shi, C.; Liu, C.; Liu, M.; Wang, L.; Sun, M.; Zhang, K.; Liu, Q.; et al. An Injectable and Thermosensitive Hydrogel: Promoting Periodontal Regeneration by Controlled-release of Aspirin and Erythropoietin. Acta. Biomater. 2019, 86, 235–246. [Google Scholar] [CrossRef]
- Zhang, C.; Hui, D.; Du, C.; Sun, H.; Peng, W.; Pu, X.; Li, Z.; Sun, J.; Zhou, C. Preparation and Application of Chitosan Biomaterials in Dentistry. Int. J. Biol. Macromol. 2021, 167, 1198–1210. [Google Scholar] [CrossRef]
- Li, Y.; Chi, Y.Q.; Yu, C.H.; Xie, Y.; Xia, M.Y.; Zhang, C.L.; Han, X.; Peng, Q. Drug-free and Non-crosslinked Chitosan Scaffolds with Efficient Antibacterial Activity Against Both Gram-negative and Gram-positive Bacteria. Carbohydr. Polym. 2020, 241, 116386. [Google Scholar] [CrossRef]
- Veltman, B.; Harpaz, D.; Cohen, Y.; Poverenov, E.; Eltzov, E. Characterization of the Selective Binding of Modified Chitosan Nanoparticles to Gram-negative Bacteria Strains. Int. J. Biol. Macromol. 2022, 194, 666–675. [Google Scholar] [CrossRef] [PubMed]
- Aranaz, I.; Mengíbar, M.; Harris, R.; Paños, I.; Miralles, B.; Acosta, N.; Galed, G.; Heras, A. Functional Characterization of Chitin and Chitosan. Curr. Chem. Biol. 2009, 3, 203–230. [Google Scholar] [CrossRef]
- Arora, S.; Das, G.; Alqarni, M.; Grover, V.; Manzoor Baba, S.; Saluja, P.; Hassan, S.A.B.; Abdulla, A.M.; Bavabeedu, S.S.; Abullais, S.S. Role of Chitosan Hydrogels in Clinical Dentistry. Gels 2023, 9, 698. [Google Scholar] [CrossRef]
- Riva, R.; Ragelle, H.; des Rieux, A.; Duhem, N.; Jérôme, C.; Préat, V. Chitosan and Chitosan Derivatives in Drug Delivery and Tissue Engineering. In Chitosan for biomaterials II; Advances in Polymer Science; Jayakumar, R., Prabaharan, M., Muzzarelli, R.A.A., Eds.; Springer: Berlin/Heidelberg, Germany, 2011; pp. 19–44. [Google Scholar] [CrossRef]
- VandeVord, P.J.; Matthew, H.W.T.; DeSilva, S.P.; Mayton, L.; Wu, B.; Wooley, P.H. Evaluation of the Biocompatibility of a Chitosan Scaffold in Mice. J. Biomed. Mater. Res. 2002, 59, 585–590. [Google Scholar] [CrossRef] [PubMed]
- Konovalova, M.V.; Markov, P.A.; Durnev, E.A.; Kurek, D.V.; Popov, S.V.; Varlamov, V.P. Preparation and Biocompatibility Evaluation of Pectin and Chitosan Cryogels for Biomedical Application. J. Biomed. Mater. Res. Part A 2017, 105, 547–556. [Google Scholar] [CrossRef] [PubMed]
- Valderruten, N.; Valverde, J.; Zuluaga, F.; Ruiz-Durántez, E. Synthesis and characterization of chitosan hydrogels cross-linked with dicarboxylic acids. React. Funct. Polym. 2014, 84, 21–28. [Google Scholar] [CrossRef]
- Guillén-Carvajal, K.; Valdez-Salas, B.; Beltrán-Partida, E.; Salomón-Carlos, J.; Cheng, N. Chitosan, Gelatin, and Collagen Hydrogels for Bone Regeneration. Polymers 2023, 15, 2762. [Google Scholar] [CrossRef]
- Kmiec, M.; Pighinelli, L.; Tedesco, M.F. Chitosan-properties and Applications in Dentistry. Adv. Tissue. Eng. Regen. Med. Open Access 2017, 2, 205–211. [Google Scholar] [CrossRef]
- Calixto, G.M.F.; de Annunzio, S.R.; Victorelli, F.D.; Frade, M.L.; Ferreira, P.S.; Chorilli, M.; Fontana, C.R. Chitosan-Based Drug Delivery Systems for Optimization of Photodynamic Therapy: A Review. AAPS PharmSciTech 2019, 20, 253. [Google Scholar] [CrossRef]
- Narvaez-Flores, J.J.; Vilar-Pineda, G.; Acosta-Torres, L.; Garcia-Contreras, R. Cytotoxic and Anti-inflammatory Effects of Chitosan and Hemostatic Gelatin in Oral Cell Culture. Acta Odontol. Latinoam. 2021, 34, 98–103. [Google Scholar] [CrossRef]
- Ebhodaghe, S.O. A Short Review on Chitosan and Gelatin-Based Hydrogel Composite Polymers for Wound Healing. J. Biomater. Sci. Polym. Ed. 2022, 33, 1595–1622. [Google Scholar] [CrossRef] [PubMed]
- Chaudhry, G.E.; Thirukanthan, C.S.; NurIslamiah, K.M.; Sung, Y.Y.; Sifzizul, T.; Effendy, A. Characterization and Cytotoxicity of low-Molecular-Weight Chitosan and Chito-Oligosaccharides Derived From Tilapia Fish Scales. J. Adv. Pharm. Technol. Res. 2021, 12, 373–377. [Google Scholar] [CrossRef] [PubMed]
- Movaffagh, J.; Fazly Bazzaz, B.S.; Yazdi, A.T.; Sajadi-Tabassi, A.; Azizzadeh, M.; Najafi, E.; Amiri, N.; Taghanaki, H.B.; Ebrahimzadeh, M.H.; Moradi, A. Wound Healing and Antimicrobial Effects of Chitosan-hydrogel/Honey Compounds in a Rat Full-thickness Wound Model. Wounds 2019, 31, 228–235. [Google Scholar]
- Gohil, S.V.; Padmanabhan, A.; Kan, H.M.; Khanal, M.; Nair, L.S. Degradation-Dependent Protein Release from Enzyme Sensitive Injectable Glycol Chitosan Hydrogel. Tissue Eng. Part A 2021, 27, 13–14. [Google Scholar] [CrossRef] [PubMed]
- Kim, S.; Fan, J.; Lee, C.S.; Lee, M. Dual Functional Lysozyme-Chitosan Conjugate for Tunable Degradation and Antibacterial Activity. ACS Appl. Bio Mater. 2020, 20, 2334–2343. [Google Scholar] [CrossRef] [PubMed]
- Poblet, E.; Jimenez-Acosta, F.; Rocamora, A. QBEND/10 (anti-CD34 antibody) in External Root Sheath Cells and Follicular Tumors. J. Cutan. Pathol. 1994, 21, 224–228. [Google Scholar] [CrossRef]
- Perczel-Kovách, K.; Hegedűs, O.; Földes, A.; Sangngoen, T.; Kálló, K.; Steward, M.C.; Varga, G.; Nagy, K.S. STRO-1 Positive Cell Expansion During Osteogenic Differentiation: A Comparative Study of Three Mesenchymal Stem Cell Types of Dental Origin. Arch. Oral Biol. 2021, 122, 104995. [Google Scholar] [CrossRef]
- Denkbaş, E.B.; Ozturk, E.; Ozdemir, N.; Kececi, K.; Agalar, C. Norfloxacin-loaded chitosan sponges as wound dressing material. J. Biomater. Appl. 2004, 18, 291–303. [Google Scholar] [CrossRef]
- Matica, M.A.; Aachmann, F.L.; Tøndervik, A.; Sletta, H.; Ostafe, V. Chitosan as a Wound Dressing Starting Material: Antimicrobial Properties and Mode of Action. Int. J. Mol. Sci. 2019, 20, 5889. [Google Scholar] [CrossRef]
- Patel, M.; Nakaji-Hirabayashi, T.; Matsumura, K. Effect of dual-drug-releasing micelle-hydrogel composite on wound healing in vivo in full-thickness excision wound rat model. J. Biomed. Mater. Res. A 2019, 107, 1094–1106. [Google Scholar] [CrossRef]
- Ahmad, M.; Bushra, R.; Ritzoulis, C.; Meigui, H.; Jin, Y.; Xiao, H. Molecular characterisation, gelation kinetics and rheological enhancement of ultrasonically extracted triggerfish skin gelatine. J. Mol. Struct. 2024, 1296 Pt 2, 136931. [Google Scholar] [CrossRef]
- Li, H.; Wan Mustapha, W.A.; Tian, G.; Dong, N.; Zhao, F.; Zhang, X.; Long, D.; Liu, J. Enhanced hydrophobic interaction between fish (Cyprinus carpio L.) scale gelatin and curcumin: Mechanism study. Food Chem. 2024, 431, 137102. [Google Scholar] [CrossRef] [PubMed]
- Rahmatpour, A.; Alijani, N. An all-biopolymer self-assembling hydrogel film consisting of chitosan and carboxymethyl guar gum: A novel bio-based composite adsorbent for Cu2+ adsorption from aqueous solution. Int. J. Biol. Macromol. 2023, 242(Pt2), 124878. [Google Scholar] [CrossRef] [PubMed]
- Rostami, M.S.; Khodaei, M.M. Recent advances of chitosan-based nanocomposites for supercapacitor applications: Key challenges and future research directions. J. Energy Storage 2023, 72 Pt B, 108344. [Google Scholar] [CrossRef]
- Sethi, S.; Thakur, S.; Sharma, D.; Singh, G.; Sharma, N.; Kaith, B.S.; Khullar, S. Malic acid cross-linked chitosan based hydrogel for highly effective removal of chromium (VI) ions from aqueous environment. React. Funct. Polym. 2022, 177, 105318. [Google Scholar] [CrossRef]
- Sutthasupa, S.; Koo-amornpattana, W.; Worasuwannarak, N.; Prachakittikul, P.; Teachawachirasiri, P.; Wanthong, W.; Thungthong, T.; Inthapat, P.; Chanamarn, W.; Thawonbundit, C.; et al. Sugarcane bagasse-derived granular activated carbon hybridized with ash in bio-based alginate/gelatin polymer matrix for methylene blue adsorption. Int. J. Biol. Macromol. 2023, 253 Pt 7, 127464. [Google Scholar] [CrossRef]
- Toniciolli Rigueto, C.V.; Rosseto, M.; Alessandretti, I.; de Oliveira, R.; Wohlmuth, D.A.R.; Ferreira Menezes, J.; Loss, R.A.; Dettmer, A.; Pizzutti, I.R. Gelatin films from wastes: A review of production, characterization, and application trends in food preservation and agriculture. Food Res. Int. 2022, 162 Pt B, 112114. [Google Scholar] [CrossRef]
- Yi, P.; Xu, X.; Qiu, B.; Li, H. Impact of chitosan membrane culture on the expression of pro- and anti-inflammatory cytokines in mesenchymal stem cells. Exp. Ther. Med. 2020, 20, 3695–3702. [Google Scholar] [CrossRef]
- Foroozan, M.; Roudi, R.; Abolhasani, M.; Gheytanchi, E.; Mehrazma, M. Clinical Significance of Endothelial Cell Marker CD34 and Mast Cell Marker CD117 in Prostate Adenocarcinoma. Pathol. Res. Pract. 2017, 213, 612–618. [Google Scholar] [CrossRef]
- Sakakibara, R.; Kobayashi, M.; Takahashi, N.; Inamura, K.; Ninomiya, H.; Wakejima, R.; Kitazono, S.; Yanagitani, N.; Horiike, A.; Ichinose, J.; et al. Insulinoma-associated Protein 1 (INSM1) Is a Better Marker for the Diagnosis and Prognosis Estimation of Small Cell Lung Carcinoma Than Neuroendocrine Phenotype Markers Such as Chromogranin A, Synaptophysin, and CD56. Am. J. Surg. Pathol. 2020, 44, 757–764. [Google Scholar] [CrossRef]
- Tashakkorian, H.; Hasantabar, V.; Mostafazadeh, A.; Golpour, M. Transparent chitosan based nanobiocomposite hydrogel: Synthesis, thermophysical characterization, cell adhesion and viability assay. Int. J. Biol. Macromol. 2020, 144, 715–724. [Google Scholar] [CrossRef] [PubMed]
- Yi, B.; Ding, T.; Jiang, S.; Gong, T.; Chopra, H.; Sha, O.; Dissanayaka, W.L.; Ge, S.; Zhang, C. Conversion of Stem Cells from Apical Papilla into Endothelial Cells by Small Molecules and Growth Factors. Stem. Cell Res. Ther. 2021, 12, 266. [Google Scholar] [CrossRef] [PubMed]
- Yadav, A.; Bhise, S. Chitosan: A Potential Biomaterial Effective Against Typhoid. Curr. Sci. 2004, 87, 1176–1178. [Google Scholar] [CrossRef]
- Pal, K.; Bharti, D.; Sarkar, P.; Anis, A.; Kim, D.; Chałas, R.; Maksymiuk, P.; Stachurski, P.; Jarzębski, M. Selected Applications of Chitosan Composites. Int. J. Mol. Sci. 2021, 11, 10968. [Google Scholar] [CrossRef]
- Fan, L.; Yang, H.; Yang, J.; Peng, M.; Hu, J. Preparation and characterization of chitosan/gelatin/PVA hydrogel for wound dressings. Carbohydr. Polym. 2016, 146, 427–434. [Google Scholar] [CrossRef]
- Nguyen, T.H.; Lee, B.T. The effect of cross-linking on the microstructure, mechanical properties and biocompatibility of electrospun polycaprolactone-gelatin/PLGA-gelatin/PLGA-chitosan hybrid composite. Sci. Technol. Adv. Mater. 2012, 13, 035002. [Google Scholar] [CrossRef]
- Fan, L.; Yang, J.; Wu, H.; Hu, Z.; Yi, J.; Tong, J.; Zhu, X. Preparation and characterization of quaternary ammonium chitosan hydrogel with significant antibacterial activity. Int. J. Biol. Macromol. 2015, 79, 830–836. [Google Scholar] [CrossRef]

Disclaimer/Publisher’s Note: The statements, opinions and data contained in all publications are solely those of the individual author(s) and contributor(s) and not of MDPI and/or the editor(s). MDPI and/or the editor(s) disclaim responsibility for any injury to people or property resulting from any ideas, methods, instructions or products referred to in the content. |
© 2023 by the authors. Licensee MDPI, Basel, Switzerland. This article is an open access article distributed under the terms and conditions of the Creative Commons Attribution (CC BY) license (https://creativecommons.org/licenses/by/4.0/).
Share and Cite
Flores-Espinoza, A.I.; Garcia-Contreras, R.; Guzman-Rocha, D.A.; Aranda-Herrera, B.; Chavez-Granados, P.A.; Jurado, C.A.; Alfawaz, Y.F.; Alshabib, A. Gelatin–Chitosan Hydrogel Biological, Antimicrobial and Mechanical Properties for Dental Applications. Biomimetics 2023, 8, 575. https://doi.org/10.3390/biomimetics8080575
Flores-Espinoza AI, Garcia-Contreras R, Guzman-Rocha DA, Aranda-Herrera B, Chavez-Granados PA, Jurado CA, Alfawaz YF, Alshabib A. Gelatin–Chitosan Hydrogel Biological, Antimicrobial and Mechanical Properties for Dental Applications. Biomimetics. 2023; 8(8):575. https://doi.org/10.3390/biomimetics8080575
Chicago/Turabian StyleFlores-Espinoza, Andrea Itzamantul, Rene Garcia-Contreras, Dulce Araceli Guzman-Rocha, Benjamin Aranda-Herrera, Patricia Alejandra Chavez-Granados, Carlos A. Jurado, Yasser F. Alfawaz, and Abdulrahman Alshabib. 2023. "Gelatin–Chitosan Hydrogel Biological, Antimicrobial and Mechanical Properties for Dental Applications" Biomimetics 8, no. 8: 575. https://doi.org/10.3390/biomimetics8080575
APA StyleFlores-Espinoza, A. I., Garcia-Contreras, R., Guzman-Rocha, D. A., Aranda-Herrera, B., Chavez-Granados, P. A., Jurado, C. A., Alfawaz, Y. F., & Alshabib, A. (2023). Gelatin–Chitosan Hydrogel Biological, Antimicrobial and Mechanical Properties for Dental Applications. Biomimetics, 8(8), 575. https://doi.org/10.3390/biomimetics8080575

